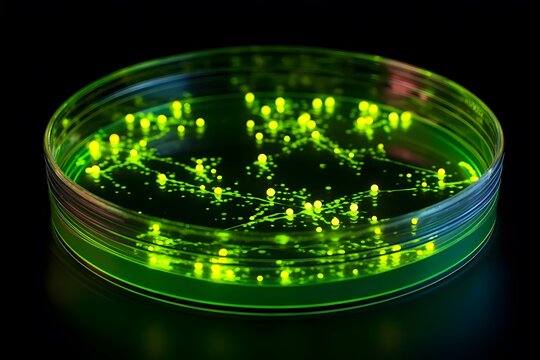
Bright green fluorescent bacteria grow in clusters on a petri dish.

- Home >
- Stock Photos >
- Modern Green Radar with Signal Lines in Black Background Illustration
Modern Green Radar with Signal Lines in Black Background Illustration Image

Digital green radar interface showing movements against a black background. Perfect for representing concepts of tracking, scanning, and technology, this visual can be used in presentations, security system designs, and technology-related communications.
2
downloads
downloads
Tags:
More
Credit Photo
If you would like to credit the Photo, here are some ways you can do so
Text Link
photo Link
<span class="text-link">
<span>
<a target="_blank" href=https://pikwizard.com/photo/modern-green-radar-with-signal-lines-in-black-background-illustration/7b2c636e6f04ea8afa87f25c56e5dee3/>PikWizard</a>
</span>
</span>
<span class="image-link">
<span
style="margin: 0 0 20px 0; display: inline-block; vertical-align: middle; width: 100%;"
>
<a
target="_blank"
href="https://pikwizard.com/photo/modern-green-radar-with-signal-lines-in-black-background-illustration/7b2c636e6f04ea8afa87f25c56e5dee3/"
style="text-decoration: none; font-size: 10px; margin: 0;"
>
<img src="https://pikwizard.com/pw/medium/7b2c636e6f04ea8afa87f25c56e5dee3.jpg" style="margin: 0; width: 100%;" alt="" />
<p style="font-size: 12px; margin: 0;">PikWizard</p>
</a>
</span>
</span>
Free (free of charge)
Free for personal and commercial use.
Author: Creative Art